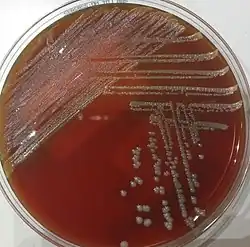

Massilia | ||
---|---|---|
![]() Massilia productora de violaceína | ||
Taxonomía | ||
Dominio: | Bacteria | |
Filo: | Pseudomonadota | |
Clase: | Betaproteobacteria | |
Orden: | Burkholderiales | |
Familia: | Oxalobacteraceae | |
Género: |
Massilia La Scola et al. 2000 | |
Especie tipo | ||
Massilia timonae | ||
Especies | ||
M. aerilata | ||
Massilia es un género de bacterias gramnegativas de la familia Oxalobacteraceae. Fue descrito en el año 2000. Su etimología hace referencia a Massilia, el nombre romano de la ciudad de Marsella, Francia.[1] Son bacterias aerobias y móviles. Se han aislado de múltiples ambientes, desde suelos, zonas gélidas como glaciares y la Antártida, zonas desérticas, agua dulce, plantas y del aire. Algunas especies, como M. timonae, M. consociata, M. haematophila, M. oculi y M. varians se han relacionado con infecciones humanas, aunque son casos poco frecuentes.
Infecciones humanas
Sólo unas pocas especies se han relacionado con infecciones en humanos: M. timonae, M. consociata, M. haematophila, M. oculi y M. varians. Principalmente se han descrito casos de bacteriemia[2][3][4], aunque también de forma anecdótica otras infecciones como linfadenopatía[5] o infecciones oculares.[6][7][8] Algunas de ellas se pueden identificar por MALDI-TOF, y son sensibles a la mayoría de antibióticos.
Taxonomía
Actualmente (2023) contiene 61 especies descritas.[9] En un estudio taxonómico, se reubicaron dentro del género Massilia[4] todas las especies que anteriormente pertenecían al género Naxibacter. Las especies actuales del género Massilia son las siguientes:
- M. aerilata
- M. agilis
- M. agri
- M. albidiflava
- M. alkalitolerans
- M. antarctica
- M. aquatica
- M. arenae
- M. arenosa
- M. armeniaca
- M. arvi
- M. atriviolacea
- M. aurea
- M. brevitalea
- M. buxea
- M. cavernae
- M. chloroacetimidivorans
- M. consociata
- M. dura
- M. eburnea
- M. eurypsychrophila
- M. flava
- M. forsythiae
- M. frigida
- M. ginsengisoli
- M. glaciei
- M. guangdongensis
- M. haematophila
- M. horti
- M. jejuensis
- M. kyonggiensis
- M. lurida
- M. lutea
- M. mucilaginosa
- M. namucuonensis
- M. neuiana
- M. niabensis
- M. niastensis
- M. norwichensis
- M. oculi
- M. phosphatilytica
- M. pinisoli
- M. plicata
- M. polaris
- M. psychrophila
- M. puerhi
- M. putida
- M. rhizosphaerae
- M. rivuli
- M. rubra
- M. soli
- M. solisilvae
- M. suwonensis
- M. terrae
- M. tieshanensis
- M. timonae
- M. umbonata
- M. varians
- M. violacea
- M. violaceinigra
- M. yuzhufengensis
Referencias
- ↑ La Scola, B.; Birtles, R. J.; Mallet, M. N.; Raoult, D. (1998-10). «Massilia timonae gen. nov., sp. nov., isolated from blood of an immunocompromised patient with cerebellar lesions». Journal of Clinical Microbiology 36 (10): 2847-2852. ISSN 0095-1137. PMID 9738031. doi:10.1128/JCM.36.10.2847-2852.1998. Consultado el 12 de febrero de 2023.
- ↑ Lindquist, David; Murrill, Donna; Burran, W. Patrick; Winans, Gloria; Janda, J. Michael; Probert, Will (2003-01). «Characteristics of Massilia timonae and Massilia timonae-like isolates from human patients, with an emended description of the species». Journal of Clinical Microbiology 41 (1): 192-196. ISSN 0095-1137. PMID 12517847. doi:10.1128/JCM.41.1.192-196.2003. Consultado el 12 de febrero de 2023.
- ↑ Kämpfer, Peter; Falsen, Enevold; Busse, Hans-Jürgen (2008-07). «Naxibacter varians sp. nov. and Naxibacter haematophilus sp. nov., and emended description of the genus Naxibacter». International Journal of Systematic and Evolutionary Microbiology 58 (Pt 7): 1680-1684. ISSN 1466-5026. PMID 18599716. doi:10.1099/ijs.0.65516-0. Consultado el 12 de febrero de 2023.
- 1 2 Kämpfer, Peter; Lodders, Nicole; Martin, Karin; Falsen, Enevold (2011-07). «Revision of the genus Massilia La Scola et al. 2000, with an emended description of the genus and inclusion of all species of the genus Naxibacter as new combinations, and proposal of Massilia consociata sp. nov». International Journal of Systematic and Evolutionary Microbiology 61 (Pt 7): 1528-1533. ISSN 1466-5034. PMID 20656816. doi:10.1099/ijs.0.025585-0. Consultado el 12 de febrero de 2023.
- ↑ Van Craenenbroeck, Amaryllis H.; Camps, Kim; Zachée, Pierre; Wu, Ka Lung (2011-07). «Massilia timonae infection presenting as generalized lymphadenopathy in a man returning to Belgium from Nigeria». Journal of Clinical Microbiology 49 (7): 2763-2765. ISSN 1098-660X. PMC 3147811. PMID 21525215. doi:10.1128/JCM.00160-11. Consultado el 12 de febrero de 2023.
- ↑ Chiquet, Christophe; Boisset, Sandrine; Pechinot, Andre; Creuzot-Garcher, Catherine; Aptel, Florent; Bron, Alain M. (2015-08). «Massilia timonae as cause of chronic endophthalmitis following cataract surgery». Journal of Cataract and Refractive Surgery 41 (8): 1778-1780. ISSN 1873-4502. PMID 26432138. doi:10.1016/j.jcrs.2015.07.016. Consultado el 12 de febrero de 2023.
- ↑ Kämpfer, Peter; Lodders, Nicole; Martin, Karin; Falsen, Enevold (2012-02). «Massilia oculi sp. nov., isolated from a human clinical specimen». International Journal of Systematic and Evolutionary Microbiology 62 (Pt 2): 364-369. ISSN 1466-5034. PMID 21441374. doi:10.1099/ijs.0.032441-0. Consultado el 12 de febrero de 2023.
- ↑ Cho, Jooyoung; Kim, Keon Han; Kim, Jung Ok; Hong, Jun Sung; Jeong, Seok Hoon; Lee, Kyungwon (2017-09). «Massilia varians Isolated from a Clinical Specimen». Infection & Chemotherapy 49 (3): 219-222. ISSN 2093-2340. PMC 5620389. PMID 28608658. doi:10.3947/ic.2017.49.3.219. Consultado el 12 de febrero de 2023.
- ↑ «Genus: Massilia». lpsn.dsmz.de. Consultado el 12 de febrero de 2023.